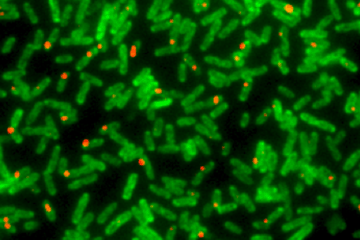

TOP > News > Researcher Profile of the Month > Yuichi Taniguchi

Having just published in Science and had his name included in a patent, some would think Yuichi Taniguchi, PI of the Laboratory for Single Cell Gene Dynamics, an unlikely candidate to leave Harvard University. However, the birth of his first child convinced him and his wife that returning to Japan was in their best interests. After considering his options, he realized QBiC to be his best choice, because “I can focus on research, not teaching. I like doing science. And the funding is great”.
Unlike his move from Harvard, Yuichi’s decision to move to Harvard was very sudden. It began when he wrote to Sunney Xie after reading two 2006 papers by the professor on stochastic protein expression. Within little more than a month, the two had come to an agreement for Yuichi to join the lab. Yuichi immediately found the style of research there to be quite different from his previous experiences, which had been entirely in Japan. There was a lot more team decisions and team discussions, which took away some of the independence to which he had grown accustomed. “This was a good thing, because I had switched to a new research field”. It was also a good thing, because Yuichi admits that while he had often heard that research was done differently in the U.S., he could finally experience the differences directly. It was his time in Boston especially that has convinced him building an international lab at QBiC is very important for research success.
Yuichi has spent his science career quantifying various biological systems using microscopy techniques, with the latest focusing on the E. coli proteome and transcriptome and measuring their activities at single-molecule sensitivity in single cells. “These techniques actually allow us to measure quantitatively the number and localization of gene expression events of the whole genome in single cells. They also offer to monitor the dynamics of the events in living cells over a relatively long period of time. I very much expect such quantified descriptions will have a major impact on our understanding of biological or disease processes”. Yuichi is now trying to expand his proteins and organisms of interest by developing a combined high-throughput system and single-molecule fluorescent microscope. It is a comprehensive study that requires a team with backgrounds in cell biology, microscopy, microfabrication, and omics.
Simultaneous observation of single-molecule mRNA (red) and protein (green) expressions in single Escherichia coli cells using single-molecule fluorescent microscopy.
Yuichi is one of QBiC’s leading examples of the institute’s concerted effort to giving young researchers leadership roles. That at times can be overwhelming, as in addition to the responsibilities of acquiring research results, Yuichi must manage the lab and recruit new members, keeping him in a perpetual state of busyness. “It will probably be at least a year, maybe two until we publish”. Of course, these are the challenges that accompany any researcher starting up his/her own lab for the first time. Regardless, he is very optimistic that the scientific environment here will facilitate discoveries he could not make elsewhere. “QBiC lacks the hierarchical organization often seen in Japan, which makes it much easier to carry scientific discussion. As a result, we work more closely with colleagues to take on more ambitious projects. It is also why we have such a diversity of science backgrounds, from hardcore theorists to the wettest of cell biologists. I really believe QBiC will be a leader in new theories that explain how cells function and age”.